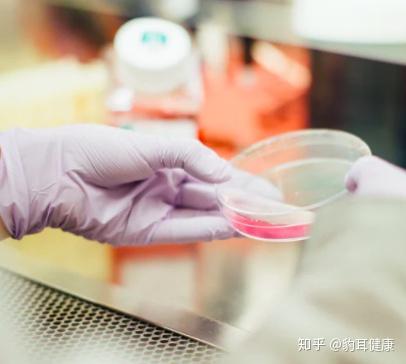
肺癌晚期补硒400(晚期肺癌补硒400毫克)-硒宝网

肺癌晚期补硒400(晚期肺癌补硒400毫克)
8月5日港媒报道,香港演员曾志伟的太太朱锡珍因癌症去世。据悉,朱锡珍早前发现癌症经治疗后好转,但今年5月份再度入院,短短三个月就死亡。
癌症似乎一发现,病情恶化的就特别快,这是因为大多数的癌症,在发现时已经到了晚期。

大家都有这样的疑惑,每年都在体检,花的钱也不少,每次体检报告上各项指标没有任何异常。可是总能见到体检健康的人,突然到了癌症晚期,没多久就撒手人寰了。
是癌症来的太快,还是体检根本不管用?

我们每年做的普通体检,只能对自己的身体健康状况和重要器官运行是否正常有一个初步的印象,对一些常见的慢性病比如心脑血管疾病筛选比较有用,对于中晚期比较严重的癌症也会有一个指示作用。
这类体检不是针对癌症设计的,而且有的癌症早期没有任何症状,所以想要通过普通体检查出处于早期的癌症,几乎不太可能。

其实,有些癌症在早期时,已经给了我们信号。但这些信号具有欺骗性,有些会被误认为其他疾病,耽误治疗?;褂行┎∪硕孕∶〔恢厥?,抱着能忍就忍的心态,等到发展成晚期了,后悔莫及。
中国中医科学院主任医师张文彭,将早期癌症发出的信号,总结成了五个字:血、块、痛、烧、减。

一、血。
除了女性正常的经血,无论哪个器官无缘无故的出血,还久治不愈,都可能是癌症的早期预警信号。
尿血可能是尿路感染,也可能是肾癌、膀胱癌;
便血可能是痔疮,也可能是直肠癌;
经期之外的阴道出血,可能是子宫内膜癌、宫颈癌;
吐血咳血可能是胃癌、食道癌、肺癌;
过度淤血或出血不止可能是白血病。

二、块。
身体浅表部短时间内有快速变大或一直都不消的肿块,癌肿一般是没有规则的肿块,有瘙痒、渗出、溃烂等;
甲状腺肿、声音突然嘶哑或突然声音发不出,不仅要检查甲状腺状况,还应检查是否有肿瘤,防止喉癌、甲状腺癌漏诊;
乳房两侧不对称,肿块不规则,有橘皮样改变,或许是乳腺癌。

三、痛。
如果胸口疼痛蔓延到肩部、臀部,并且持续超过6周,可能是喉癌、甲状腺癌、食道癌、肺癌;
如果长期出现腰疼、腹部有肿块以及尿血的现象,要当心肾癌;
小腹莫名胀痛可能是卵巢癌;
盆腔剧烈疼痛可能是纤维瘤、卵巢囊肿及其他生殖系统疾病的共同症状;
饭后莫名胃疼、肚子胀可能是胃癌的征兆;
身体出现莫名的疼痛持续4周以上,当心骨癌或睾丸癌。

四、烧。
癌症会影响到免疫系统,从而造成持续的发烧和感染,有些癌症还会让人持续疲劳。不明原因的持续低烧可能是淋巴癌、肾癌、肝癌的征兆。
五、减
除了糖尿病和甲亢患者,短时间内体重迅速下降是癌症的第一信号。
在乳腺癌和肺癌患者中最常见,还有可能是肝癌和肠癌。

中国医学科学院肿瘤医院防癌科主任王建璋还提示,吞咽困难通常与喉癌、食道癌有关。
皮肤或眼白突然发黄,通??悸鞘歉卧嗷虻业募膊?,但也可能是胰腺癌、胆管癌、肝癌的症状。
如果皮肤突然长出新的斑点,或者黑痣的外观产生变化,以及皮肤的疮口总不愈合,结痂但容易出血,应该当心皮肤癌。

如果出现了上述症状,或者没有症状但想检查一下以求心安,应该做哪些检查呢?
针对不同的癌症,应该做相应的癌症筛查:
1.肺癌
高危人群:50岁以上,吸烟超过400支;
推荐:低剂量螺旋CT,每年一次。

2.肝癌
高危人群:40岁以上,有慢性肝病史,长期酗酒,重度脂肪肝,有家族病史;
推荐:腹部B超+,血清甲胎蛋白(AFP)检查。
3.胃癌
高危人群:40岁以上,幽门螺杆菌感染者,有家族病史,慢性胃病,酗酒吸烟,高盐饮食;
推荐:胃镜。
4.乳腺癌
高危人群:有家族病史,进行过胸部放射治疗;
推荐:乳腺钼靶,乳腺B超,每年一次,20岁即可筛查。
5.宫颈癌
高危人群:35~50岁,感染或曾经感染HPV病毒,宫颈不典型增生,早孕多孕;
推荐:TCT检查,HPV检查。

6.结肠癌、直肠癌
高危人群:40~74岁,慢性肠炎、肠息肉,有家族病史;
推荐:肠镜。
7.鼻咽癌
高危人群:30~65岁,EB病毒(一种疱疹病毒)感染者,有家族病史,颈部有异常肿块;
推荐:鼻咽镜。

8.前列腺癌
高危人群:65岁以上男性,有家族病史;
推荐:前列腺特异性抗原(PSA)项目。
